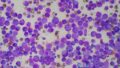

犬猫の免疫介在性血小板減少症
血小板について
血液は出血したら時間とともに固まる性質があります。その止血にかかわる役割の一助を担っているのが血小板です。特に一次止血という重要なポジションになっています。血小板が多いことで問題となることはあまりありませんが、減少すると出血傾向といい、出血が止まらなくなるといった問題が起こることがあります。特に出血を伴うような手術前では血小板がしっかりあることが大変に重要です。
免疫介在性血小板減少症
その止血に重要な血小板が、犬や猫では突如として、激減してしまうことがあります。ひとつは大出血を生じたときなのですが、もうひとつが免疫介在性血小板減少症となります。
免疫介在性ということで、これは自己免疫疾患のひとつであり、自分自身の問題となります。一種のアレルギー反応であり、本来自身の一部であるはずの血小板を異物や病原体のように認識してしまい、白血球が攻撃してしまうことで血小板が破壊されてしまいます。破壊された血小板は止血機能を失い、動物の体は出血傾向という状態に陥ってしまいます。
原因
免疫介在性血小板減少症に罹患する原因や理由ははっきりはしていません。似ている病態である免疫介在性溶血性貧血では草木や虫などが増える春から夏にかけて発症しやすいとは言われます。アレルゲンが増える時期に発症しやすい傾向がありますが、血小板減少症でも同じようなイメージかもしれません。ただ、秋でも冬でも発症する可能性がないわけではありません。何かアレルギーが過敏に反応することがあれば、その時に自分自身を攻撃するようになってしまうかもしれません。
症状
血小板減少症はちょっとしたことでは症状は出にくいため、発見が遅れるケースもあります。初期症状としては発熱や元気消失・食欲減退などが認められます。出血傾向が強くなると、血便や血尿、鼻血といった症状が出ることもあります。また、腹部など体表に紫斑というアザが出てくることもあります。突然、体に複数のアザが出てきて、なんとなく元気がないときは血小板減少症を強く疑うサインとなります。

下腹部に紫斑が出てる子の写真になります。毛に埋もれて分かりにくい時もありますが、誰かに殴られたような跡が出てくることがあります。気づきにくいですが、重要な臨床症状のひとつです。
治療
免疫介在性疾患ではその暴走した免疫を抑制することが重要になります。具体的にはステロイド剤や免疫抑制剤を使用した治療が基本となります。初期治療が功を奏して状態が改善した場合でも投薬を永続的に続けるケースもあります。飲み薬などがどの程度必要となるかは個体差が大きく、状況によります。
また、出血傾向が強い時に重度の貧血状態となることもあります。その時は輸血という処置が必要になることもあります。動物医療では輸血の際にドナーの存在が問題となることが多々あります。当院では地域の方と協力して、輸血などを実施することが多くあります。本症で命を奪われることがあるのがこの出血傾向で、貧血が過度になると呼吸停止を引き起こすことがあります。